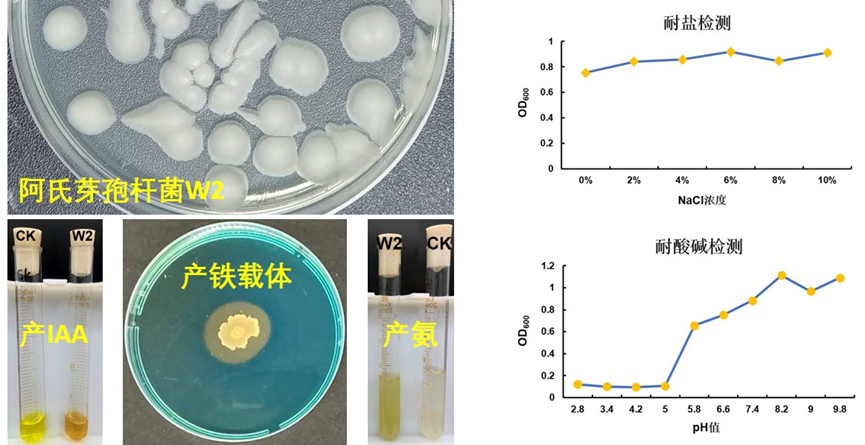

所在位置:首页 > 科学研究 > 草业研究中心 > 永盈彩票1个草坪草根际促生菌株专利成功授权并转让
所在位置:首页 > 科学研究 > 草业研究中心 > 永盈彩票1个草坪草根际促生菌株专利成功授权并转让
 574
574
 草业研究中心
草业研究中心
 2024.12.05
2024.12.05
根际促生菌泛指能够直接或间接促进植物生长、增加作物产量、防止病虫害的根际微生物,在农业生产上施用以此制备成的微生物菌剂,可以提高根际土壤养分、促进作物生长以及提高作物抗病力,进而提高作物产量和品质,从而达到减肥减药的目的。
永盈彩票草业研究中心自2021年起开展了草坪草根际促生菌的筛选工作,从草坪草健康植株的根际土壤中筛选分离到了一株阿氏芽孢杆菌(Bacillus aryabhattai)菌株W2,该菌株具有优异的耐盐碱、产IAA、产铁载体以及产氨的功能;发酵性能好,发酵液中活菌数量高;利用该菌株能达到促进草坪草生长发育、快速成坪的效果。2024年2月,以该菌株申请的国家发明专利获得授权,王晶晶助理研究员为第一发明人。近日,该成果已经成功实现企业转化。

图1 阿氏芽孢杆菌W2对三种草坪草的促生作用
图2 阿氏芽孢杆菌W2的生理生化特性

图3 阿氏芽孢杆菌W2的授权专利证书